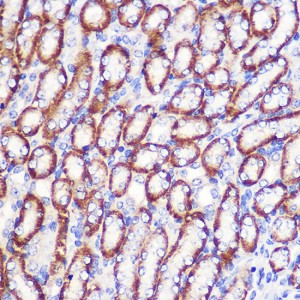
KD-Validated LDHA Rabbit pAb (20 μl)

| Reactivity: | Human, Mouse |
| Applications: | WB, IHC, IF/IC, ELISA |
| Host Species: | Rabbit |
| Isotype: | IgG |
| Clonality: | Polyclonal antibody |
| Gene Name: | actate dehydrogenase A |
| Gene Symbol: | LDHA |
| Synonyms: | LDHM; GSD11; PIG19; HEL-S-133P; LDHA |
| Gene ID: | 3939 |
| UniProt ID: | P00338 |
| Immunogen: | A synthetic peptide corresponding to a sequence within amino acids 1-100 of human LDHA (NP_001158886.1). |
| Dilution: | WB 1:500-1:1000; IHC 1:50-1:200; IF/IC 1:100-1:500 |
| Purification Method: | Affinity purification |
| Concentration: | 0.49 mg/mL |
| Buffer: | PBS with 0.05% proclin300, 50% glycerol, pH7.3. |
| Storage: | Store at -20°C. Avoid freeze / thaw cycles. |
| Documents: | Manual-LDHA polyclonal antibody |
Background
The protein encoded by this gene catalyzes the conversion of L-lactate and NAD to pyruvate and NADH in the final step of anaerobic glycolysis. The protein is found predominantly in muscle tissue and belongs to the lactate dehydrogenase family. Mutations in this gene have been linked to exertional myoglobinuria. Multiple transcript variants encoding different isoforms have been found for this gene. The human genome contains several non-transcribed pseudogenes of this gene.
Images
 | Western blot analysis of various lysates using [KD Validated] LDHA Rabbit pAb (A18574) at 1:1000 dilution. Secondary antibody: HRP-conjugated Goat anti-Rabbit IgG (H+L) (AS014) at 1:10000 dilution. Lysates / proteins: 25 μg per lane. Blocking buffer: 3 % nonfat dry milk in TBST. Detection: ECL Basic Kit (RM00020). Exposure time: 60s. |
 | Western blot analysis of lysates from wild type (WT) and LDHA knockdown (KD) 293T cells using [KD Validated] LDHA Rabbit pAb (A18574) at 1:1000 dilution. Secondary antibody: HRP-conjugated Goat anti-Rabbit IgG (H+L) (AS014) at 1:10000 dilution.Lysates/proteins: 25 μg per lane. Blocking buffer: 3% nonfat dry milk in TBST. Detection: ECL Basic Kit (RM00020). Exposure time: 60s. |
 | Immunohistochemistry analysis of paraffin-embedded Mouse kidney using [KD Validated] LDHA Rabbit pAb (A18574) at dilution of 1:100 (40x lens). Microwave antigen retrieval performed with 0.01M PBS Buffer (pH 7.2) prior to IHC staining. |
 | Immunofluorescence analysis of L929 cells using [KD Validated] LDHA Rabbit pAb (A18574) at dilution of 1:100. Secondary antibody: Cy3-conjugated Goat anti-Rabbit IgG (H+L) (AS007) at 1:500 dilution. Blue: DAPI for nuclear staining. |
You may also be interested in: